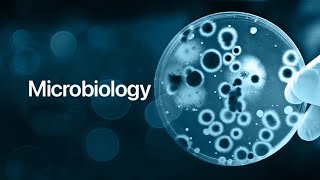

Shared 1 year ago
28 views
Shared 1 year ago
36 views
Shared 1 year ago
1.5K views
Shared 1 year ago
227 views
Shared 2 years ago
10 views
Shared 1 year ago
122 views
Shared 3 years ago
20 views
Shared 2 years ago
354 views
Shared 3 years ago
16 views
Shared 1 year ago
177 views
Gram postive cocci #staphylococcus with simplified notes #bscnursing #microbiology important10markqp
Shared 11 months ago
266 views
Shared 11 months ago
194 views
Shared 1 year ago
155 views
Shared 2 years ago
26 views
Best books for microbiology and adult health nursing #3rdsemexam #bscnursing #medicalsurgicalnursing
Shared 11 months ago
373 views
Shared 1 year ago
136 views
Shared 11 months ago
84 views
Shared 11 months ago
161 views
Shared 1 year ago
225 views
Shared 1 year ago
174 views
Shared 1 year ago
84 views
Shared 1 year ago
146 views
Shared 1 year ago
99 views
Shared 1 year ago
113 views
Shared 1 year ago
117 views